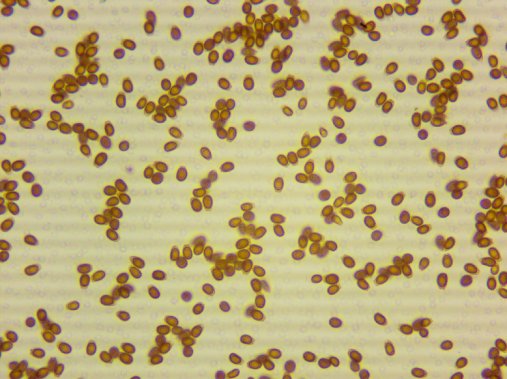

安拓思納米技術(蘇州)有限公司
 金牌會員
金牌會員 已認證
已認證

安拓思納米技術(蘇州)有限公司
 金牌會員
金牌會員 已認證
已認證
粉碎是中藥材加工和中藥制劑生產工藝中的重要環(huán)節(jié),中藥的主要藥效成分通常分布于細胞內與細胞間隙中,且以細胞內為主。傳統(tǒng)粉碎方法往往無法滿足現代制藥對粒度、均勻性和藥效的高要求,因此人們開始越來越關注超微粉碎技術在中藥中的開發(fā)與應用。
超微粉碎對中藥粉體性質的影響
1.超微粉碎對中藥粉體比表面積、孔隙度及流動性的影響
在研究中發(fā)現,隨著粉體粒徑的減小,骨碎補、三七等中藥粉體的比表面積和孔隙度增加,休止角和壓縮指數增大,表明比表面積和孔隙度均與粒度成正相關,流動性與粒度成負相關。
2.超微粉碎對中藥粉體中有效成分含量的影響
隨著粉體粒徑的減小,當歸粉體中阿魏酸的含量顯著降低,這可能是由于阿魏酸的穩(wěn)定性較差; 冰片中龍腦和異龍腦含量顯著降低,這可能是由于冰片中的成分易揮發(fā)。其余血竭、大黃等大部分中藥粉體中有效成分的含量與細粉相比,均未發(fā)生明顯變化。因此,對含有不穩(wěn)定和揮發(fā)性成分的藥材,采用超微粉碎應慎重,在粉碎時,應控制粉碎時間,或采用低溫粉碎以減少其有效成分的損失和揮發(fā)。
3.超微粉碎對中藥粉體溶出行為的影響
活性成分易溶、無細胞結構的藥材無需超微粉碎。活性成分難溶、無細胞結構藥材的各粒度粉體活性成分的溶出存在顯著差別。 有細胞結構的藥材,無論活性成分是否難溶,微粉化后均有利于其活性成分的溶出,均宜進行超微粉碎。
1.增大比表面積 ,加快溶出 ,提高生物利用度
粒徑是影響有效成分溶出的關鍵因素,超微顆粒具有表面效應、體積效應、量子效應和宏觀隧道效應 ,使其對物質的吸附性較大 ,因而微粉中藥對腸壁的黏附作用增強 ,使中藥粉粒增加了在腸內的停留時間 , 有利于藥物的吸收。
2.保留生物活性成分 ,提高藥效
在超微粉碎過程中 ,經控制可不產生過熱現象 ,甚至可在低溫狀態(tài) 下進行 ,并且粉碎速度快 ,有利于保留不耐高溫的生物活性成分及各種營養(yǎng)成分 ,從而提高藥效。
3.服用劑量減少 ,節(jié)省中藥材資源
中藥經超微處理后 ,可用較小的劑量獲得原**療效。一般藥物 ,經超微粉碎后可不再經過浸提、煎煮等處理 ,簡化了提取過程 ,縮短了提取時間 ,減少了有效成分的損失 ,根據藥材性質和粉碎度的不同 ,一般可節(jié)省藥材 30% ~70% 。
4.有效成分均勻分布,提高作用效果
中藥大多是復方 ,細胞破壁后 ,細胞內的水分及油遷出 ,使微粒表面呈半濕狀態(tài) ,粒子與粒子之間形成較穩(wěn)定的粒子團 ,每個粒子團都含有相同比例的中藥成分。這種結構使中藥材有效成分均勻化 ,均勻地在體內吸收 ,從而增強藥效。
根據粉碎過程中物料載體種類的不同又分為干法粉碎和濕法粉碎。干法粉碎有氣流式、高頻振動式、旋轉球(棒)磨式、錘擊式和自磨式等幾種形式;濕法粉碎主要是膠體磨和均質機。
近年來,高壓均質機憑借其獨特的工作原理和顯著優(yōu)勢,逐漸在中藥粉碎領域嶄露頭角。高壓均質法是利用高壓均質機中的物料通過高壓均質閥時,在加壓和驟然失壓過程產生的高速剪切和沖擊現象使互不相溶的液-液或液-固等實驗材料粉碎成極小的、均勻的狀態(tài)。通過調節(jié)設備使用的壓力和次數,達到不同的使用目的。
靈芝孢子粉破壁

破壁率與均質次數和壓力呈正相關
柴達木枸杞葉有效成分提取
采用高壓均質提取法,蘆丁含量高于回流法、超聲法和微波法,且該方法操作簡便,不需加熱,所得提取產物生理活性高。

ATS安拓思二十三年專注高壓均質機研發(fā)生產,粉碎效率高,物料均一度高,操作簡單。ATS建有全套的復雜制劑納米化設備研究中心,支持客戶來樣寄樣,解決工藝痛點,提供全系列的高壓均質機產品,可支持從實驗室到生產的不同規(guī)模應用。

?粉碎率高,粉碎時間短
?內置冷卻系統(tǒng),精準控溫
?粒徑分布范圍窄,勻度高
?配件耐腐蝕耐磨損,使用壽命長
?最大4000L/H
ATS案例
中藥粉碎

靈芝孢子粉粉碎

通過使用ATS高壓均質機,可以有效控制中藥粒徑和分布,改善中藥加工性能; 提高中藥制劑的均勻性; 加快中藥活性成分的溶出、提高溶出率,使吸收速度和程度增大,最大化保留有效成分、釋放有效物質,并適應劑型制作需要。
參考文獻:
1.汪 濤 ,孫 亮, 梁蓉梅.中藥超微粉碎的研究進展與應用前景[J]. 藥學實踐雜志,2007, 25(3):129-133.
2.趙國巍,梁新麗,廖正根,熊志偉,李哲,羅娟.超微粉碎技術對中藥粉體性質的影響[J]. 世界中醫(yī)藥,2015,10(3):315-321.
3.劉春延, 張國財, 程方志, 等. 靈芝孢子粉破壁工藝優(yōu)化及其抗腫瘤作用[J]. 食品科學, 2016, 37(14): 51-55.
4.劉增根,黨軍,江磊,邵赟,梅麗娟,陶燕鐸.柴達木枸杞葉有效成分高壓均質提取及純化[J]. 精細化工,2 8(4) :351-354.
相關產品
更多
相關文章
更多
技術文章
2025-10-22技術文章
2025-09-25技術文章
2025-09-22技術文章
2025-09-11
虛擬號將在 秒后失效
使用微信掃碼撥號